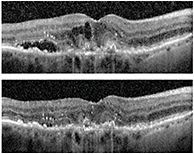

TECH TALK
The Central Role of OCT
This already indispensable modality for diagnosing and tracking disease is poised to expand in the near future.
BY CHARLES C. WYKOFF, MD, PHD, FACS
It’s difficult to overstate the importance of OCT in helping physicians diagnose and track ocular pathology. Other modalities can provide unique information, for example physiologic data not obtained with OCT, but they can’t replace OCT as a cornerstone clinical management tool. It’s the essential modality that allows us to visualize retinal anatomy in incredible detail — detail we simply can’t appreciate with any other modality, including direct visual examination.
QUANTIFYING PATHOLOGY
Beyond visualizing retinal detail, OCT enables us to quantify pathologies. We can measure thicknesses such as the central macular thickness and the retinal nerve fiber layer, quantify surface areas such as atrophic retinal pigment epithelium, quantify volumes such as pigment epithelial detachments, subretinal fluid and drusen.
DISEASE PROGRESSION
Perhaps most importantly for retina specialists, OCT delivers the vital ability to accurately track treatment effects and disease progression over time. OCT allows point-to-point comparison of the same locations on follow-up examinations over the course of months and years for diseases such as age-related macular degeneration (AMD) and diabetic macular edema. We’re able to view disease states longi-tudinally and assess changes and trends. The data guide treatment decisions and help us adjust strategies for the best results.
For example, many clinical trials have validated the use of OCT-based decision-making in determining when to re-treat patients with exudative diseases of the retina, such as wet AMD and retinal venous occlusive disease. Additionally, most of the ongoing dry AMD clinical trials include detailed quantification analyses of areas of geographic atrophy over time in the hopes of identifying pharmaceuticals that can slow its well-characterized progression.
EDUCATING PATIENTS
We also employ OCT images to help explain to patients their disease and the goals of their treatment. In particular, illustrating for patients changes in their eyes over time helps emphasize why they may benefit from treatment, which can improve patient compliance.
Figure 1. A 75-year-old Caucasian female with 2-week history of visual loss in her right eye. Examination identified neovascular AMD OD. SD-OCT at baseline (top) revealed intra-retinal and subretinal fluid with drusen. SD-OCT at follow-up (bottom), after initiation of ranibizumab, revealed improved macular edema with focal pocket of residual subretinal fluid.
EXPANDING ROLES
The central role of OCT in diagnosing, visualizing and tracking disease seems unlikely to change. However, in the future, we can look forward to additional OCT applications that may make it even more indispensable to use. OCT-based retinal and choroidal angiography and more consistent choroidal imaging will likely continue to shed light on our understanding of many retinal diseases. Broader OCT imaging of the retinal periphery would also be valuable, allowing detailed wide-field imaging of the vitreous base and associated pathologies. Finally, intraoperative OCT is an exciting frontier, poised to make a technology that’s critical now, even more essential in the future. NRP

|
|









